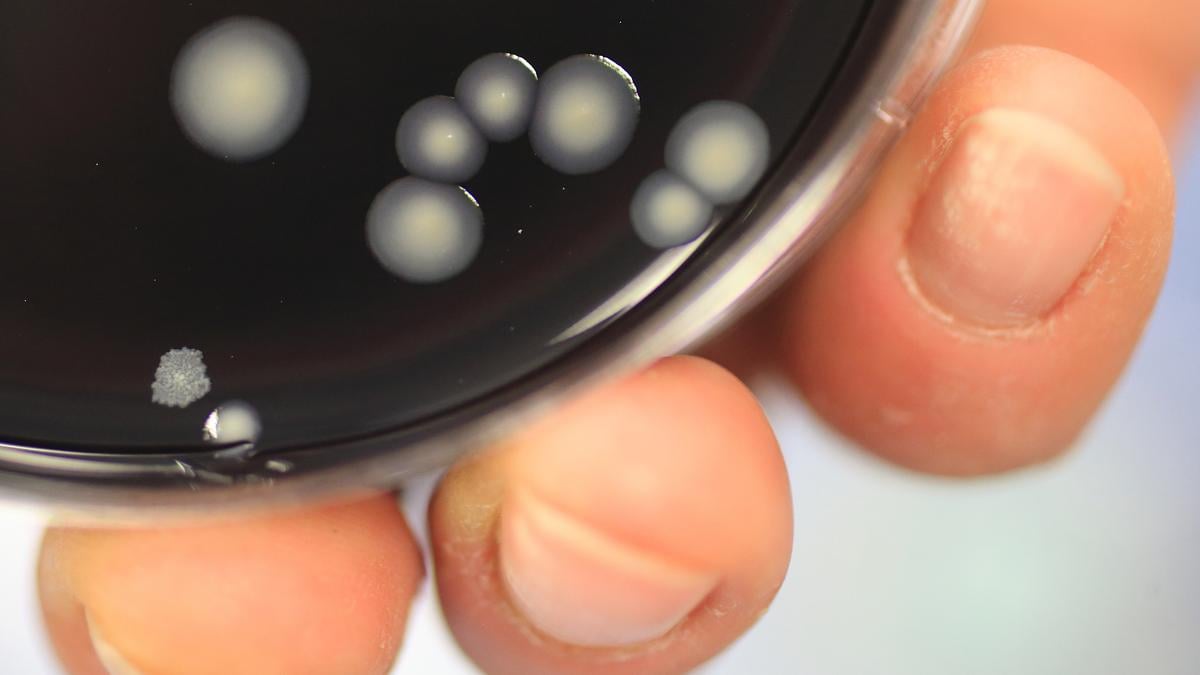

O Ministério da Saúde e a Comuna de Steinfort revelaram, na terça-feira, que as análises realizadas na rede de abastecimento de água potável e nos reservatórios de Steinfort e Kleinbettingen não detetaram a presença da bactéria legionella.
Este resultado surge após a confirmação, no início de julho, de três casos de legionella no Hospital Intercomunal de Steinfort, que deu origem a uma investigação para encontrar a origem da contaminação. Ao todo, a bactéria provocou pneumonia em oito pessoas na região entre 4 e 9 de julho.
Com a confirmação da ausência de legionela na rede pública, foram levantadas as restrições ao uso do duche para pessoas com mais de 65 anos ou com o sistema imunitário debilitado, que estavam em vigor como medida preventiva.
Confirmados três casos de legionella no Hospital Intercomunal de Steinfort
Além disso, a linha de contacto criada devido ao surto de legionella foi desativada. A população pode continuar a contactar a inspeção sanitária através do número habitual 247-85650 ou, fora do horário, pelo número de emergência 112.
A Direção da Saúde, o Laboratório Nacional de Saúde e a Administração da Gestão da Água e outros organismos vão continuar a investigação para determinar a origem exata da contaminação e para avaliar os riscos futuros.
Newsletter EM CIMA DA ATUALIDADE
Uma seleção dos principais acontecimentos para terminar o dia.
Sie können sich jederzeit wieder abmelden, wenn Sie das möchten. Weitere Informationen finden Sie in unserer Datenschutzrichtlinie.